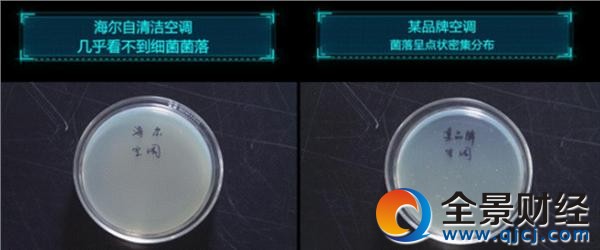

海尔自清洁空调吹“无菌空气” 全球品质节全系亮相
空调业将从“净化空气”进入到“无菌空气”的新时代。普通空调虽然能净化掉空气中的PM2.5、甲醛等有害物质,但难以从根本上清除蒸发器上滋生的细菌。305全球品质节期间,海尔智能空调将向全球用户讲一个品质故事,以全系列智能自清洁空调从源头抑制病菌滋生,防止空气二次污染。海尔智能自清洁空调几乎能吹“无菌空气”,这是真的吗?
2月22日,海尔空调推出一则《真的吗》视频,对海尔自清洁空调和普通空调进行换热器翅片细菌对比试验。经过48小时细菌培养后,普通空调样本菌落密集,而海尔自清洁空调则几乎没有任何细菌。据了解,基于用户对健康空气的需求,海尔智能自清洁空调原创自清洁6大技术,强力剥离蒸发器内部污垢,实现了室内机、室外机自清洁。同时,抑制细菌滋生,抗菌率高达99.9%,有效抑制引起腹泻、呕吐的金色葡萄球菌等病菌,使自清洁空调几乎吹出“无菌空气”。自清洁空调上市以来,不仅被用户命名“会洗澡的空调”,实机演示更进入全国万余家卖场。
除了在产品品质上的精益求精外,此次全球品质节期间,海尔空调还从研发、制造、服务等维度为全球用户打造一场全流程品质盛宴。在研发领域,传统空调多采用真人进行测试,但人的情绪会影响体温的变化,使研发数据产生偏差,导致空调出风难以达到最舒适的体验。海尔空调研发人员发明智能仿生人技术,历经6000小时的精准调控,通过162个神经元传感器测试模拟20种新陈代谢模式获取更加精确的人体舒适度数据。基于该技术,海尔发明了自清洁、“自然风、感应匀风等创新技术,使有序的机械风变为随机出风的自然风,全面提升品质体验。
在制造领域,海尔空调目前已有3大互联工厂投产应用。互联网时代消费模式改变,用户更加注重品质体验。互联工厂的一大亮点便是用户信息直达工厂,实现了对用户需求的精准对接。用户可以从研发、设计、制造、物流等领域全流程可视化的参与到生产全过程。此外,互联工厂通过搭建信息化系统实现了工厂运营状况透明化,由此实现了高精度和高效率的品质提升。
在服务领域,“好空气”APP的应用是品质升级的典型表现。该APP可以实现自清洁智能提醒,更好地与用户进行交互,用户还可获得智能用电提醒、空调能耗记录、睡眠曲线等个性化私人专属服务。同时,在大数据体系支撑下,海尔空调可实现从“派单”到“抢单”的主动服务模式升级,APP自清洁清洗提醒服务。此外,在此次全球品质节期间,海尔空调还将为用户提供包括免费设计、清洗、体检、维修等服务,为用户带来更实惠的品质服务,将行业服务模式提升到新的高度。
《中国高端家电产品消费调查报告》显示,近八成消费者计划半年内购买高端家电,品质和体验是最重要的考量因素。海尔空调凭借全智能战略布局和智慧空气生态圈的支撑,在全球品质节期间为用户提供全流程品质体验,引领行业从基础消费向品质消费升级。2月初,世界权威调研机构欧睿国际发布全球互联空调数据显示,海尔互联空调(包括智能空调)全球销量第一。在中国市场,海尔已经连续3年智能空调销量第一。
【关注微信公众号:石化宝(bweipan)手机也能炒白银原油,仅需8元即可参与,快来试试吧】
-
无相关信息












